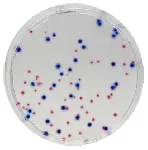

Productos
Servicios
Productos
Servicios
CHROMagar™ CCA
Medio cromogénico para la detección y recuento de E.coli ß-glucuronidasa positiva y coliformes en muestras de agua con un bajo nivel de flora acompañante (de acuerdo con la ISO 9308-1).

Medio cromogénico para la detección y recuento de E.coli ß-glucuronidasa positiva y coliformes en muestras de agua con un bajo nivel de flora acompañante (de acuerdo con la ISO 9308-1).

Características
Scharlab S.L.
F +34937152765
helpdesk@scharlab.com
Gato Pérez, 33. Pol. Ind. Mas d’en Cisa E08181 Sentmenat, Barcelona, España
T +34937456400F +34937152765
helpdesk@scharlab.com
Material de laboratorio
Productos químicos Microbiología Vidrio, cuarzo y porcelana Cromatografía Equipos Consumible Seguridad e higiene
Productos químicos Microbiología Vidrio, cuarzo y porcelana Cromatografía Equipos Consumible Seguridad e higiene

 Resto del Mundo
Resto del Mundo